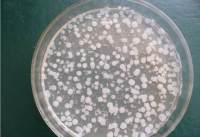
致病性大肠埃希菌图片

万千商家帮你免费找货
0 人在求购买到急需产品
- 详细信息
- 技术资料
- 库存:
28
- 英文名:
Trichoderma│tomentosum
- 保质期:
详见说明书
- 供应商:
上海邦景
- 保存条件:
低温冷藏
- 规格:
详见说明书
优势是:
1.供货及时。我们订货周期短,运输时间短,在最短时间内为您提供所需产品。
2.价格优惠:我公司是ScienCell和美国ATCC的中国代理商,没有中间环节。在国内我们保证价格最低。
3.服务保障:我们拥有专用的技术指导团队,对每售出的一件产品,提供全面的售前、售中和售后服务。
4.产品种类齐全:25个系统共150多种细胞,满足不同客户的要求。细胞经过严格的质控,纯度可达98%。常用产品备有现货。其产品类型如下:消化系统细胞株,呼吸系统细胞株,泌尿系统细胞株生殖系统细胞株 血液循环系统 内皮细胞细胞株 神经系统及其他细胞株,动物细胞株和菌株。
中文名称 绒毛木霉图片
种属 Trichoderma│tomentosum
分离基物 生物样/无瓣海桑-泥
提供形式 斜面培养物
模式菌株 no
应用领域 近海丝状真菌
培养方法
培养基 14
生长条件 25℃
存储条件 液氮超低温冻结法;-80℃冰箱冻结法
菌种的传代:
将微生物接种至一新鲜培养基上/内,每萌发一次即为一代
菌种的传代次数(自原始的菌种冻干粉起)不得超过5代
菌种保藏方法一般分四个阶段
(1)挑选特征典型的纯菌菌落
(2)能产生孢子或芽孢的微生物应用孢子或芽孢进行保存
(3)选择最适宜的方法保藏
(4)定期对保藏菌种进行检查
低温保存法:
1.简单保存法,将琼脂斜面孢子培养物、菌丝悬浮液以及由麸皮、大米、小米等谷物原料制成的孢子培养物置于4℃冰箱保存,保存时间不超过1~2个月,若将谷物原料制备的孢子瓶抽真空并在棉塞上浸蜡,以隔绝外界空气和水汽,保持时间可达3~4个月。
2.液氮超低温保存法,将生长稳定期的细胞悬浮在10%甘油或其他低冰点液体中,密封于安瓿管内,然后控制冷却速度,使安瓿管温度逐步下降至-35℃时,即可置于-150~-196℃的液氮罐中保存。大多数微生物如病毒、噬菌体、多种细菌、放线菌、酵母和原虫、特别是一些用冷冻干燥法有困难的微生物,都可用此法长期保存。
使用范围:
(1)合成培养基。合成培养基的各种成分完全是已知的各种化学物质。这种培养基的化学成分清楚,酿酒酵母菌组成成分精确,重复性强,而且微生物在这类培养基中生长较慢。如高氏一号合成培养基、察氏(Czapek)培养基等。
(2)天然培养基。由天然物质制成,如蒸熟的马铃薯和普通牛肉汤,前者用于培养霉菌,后者用于培养细菌。这类培养基的化学成分很不恒定,也难以确定,但配制方便,营养丰富,培养效果好,所以常被采用。
(3)半合成培养基。在天然有机物的基础上适当加入已知成分的无机盐类,或在合成培养基的基础上添加某些天然成分,如培养霉菌用的马铃薯葡萄糖琼脂培养基。这类培养基能更有效地满足微生物对营养物质的需要。
疏展香茶菜宁B HPLC≥95% 20mg Ratghcagons-likepepfide1,GLP-1ELISAKit大鼠胰高血糖素样肽1(Glp-1)ELISA试剂盒规格:96T/48T
延命草素 HPLC≥95% 20mg Ratghcagons-likepepfide1,GLP-1ELISA试剂盒大鼠胰高血糖素样肽1(Glp-1)ELISA试剂盒规格:96T/48T
,,三羟基',,三甲氧基黄酮 HPLC≥95% 20mg Ratglamicaciddecarboxylaseaoaibody,GAD-AbELISAKit大鼠谷氨酸脱羧酶自身抗体(GAD-Ab)ELISA试剂盒规格:96T/48T
竹红菌丙素 HPLC≥95% 20mg Ratglamicaciddecarboxylaseaoaibody,GAD-AbELISA试剂盒大鼠谷氨酸脱羧酶自身抗体(GAD-Ab)ELISA试剂盒规格:96T/48T
显轴买麻藤醇 HPLC≥95% 20mg Ratglialcellline-derivedneuroophicfactor,GDNFELISAKit大鼠胶质细胞系来源的神经营养因子(GDNF)ELISA试剂盒规格:96T/48T
甲基 O阿魏酰奎尼酸酯 HPLC≥95% 20mg Ratglialcellline-derivedneuroophicfactor,GDNFELISA试剂盒大鼠胶质细胞系来源的神经营养因子(GDNF)ELISA试剂盒规格:96T/48T
甲基 O阿魏酰奎尼酸酯 HPLC≥95% 20mg Ratglucocoicoid,GCELISAKit大鼠内源性糖皮质激素(GC)ELISA试剂盒规格:96T/48T
槲皮素O芸香糖苷 HPLC≥95% 20mg Ratglucocoicoid,GCELISA试剂盒大鼠内源性糖皮质激素(GC)ELISA试剂盒规格:96T/48T
异直立角茴香碱 HPLC≥95% 20mg Ratglucocoicoidreceptor,GRELISAKit大鼠糖皮质类受体(GR)ELISA试剂盒规格:96T/48T
直立角茴香碱 HPLC≥95% 20mg Ratglucocoicoidreceptor,GRELISA试剂盒大鼠糖皮质类受体(GR)ELISA试剂盒规格:96T/48T
补骨脂色烯查耳酮 HPLC≥95% 20mg 低分子蛋白标准样100
异补骨脂色烯查耳酮 HPLC≥95% 20mg RatOsteopoin,OPNELISA试剂盒大鼠骨桥素(OPN)ELISA试剂盒规格:96T/48T
异新补骨脂异黄酮 HPLC≥95% 20mg 小鼠细胞骨架活性调节蛋白(ARC)ELISA试剂盒 ,英文名: ARC ELISA Kit
羟基羽扇豆鹼 HPLC≥95% 20mg 兔抗内皮细胞抗体(AECA)ELISA检测试剂盒RabbitAi-endothelialcellaibodies,AECAELISAKit 96T/48T
灵芝酸TR HPLC≥95% 20mg 牛雄(ASD)试剂盒 Bovine Androstenedione,ASD ELISA Kit
灵芝烯酸A HPLC≥95% 20mg 英文名称HumanAT-IIIELISAKit人抗凝血酶(AT-III)ELISA试剂盒规格:96T/48T
灵芝酸TQ HPLC≥95% 20mg 低内小量质粒抽提试剂盒20/50
灵芝烯酸C HPLC≥95% 20mg RatOsteoprotegerinLigand,OPGLELISA试剂盒大鼠骨保护素配体(OPGL)ELISA试剂盒规格:96T/48T
Delta avenasterol HPLC≥95% 20mg 小鼠细胞分裂周期因子25(CDC25)ELISA试剂盒 ,英文名: CDC25 ELISA Kit
Delta avenasterol HPLC≥95% 20mg 兔抗平滑肌抗体(ASMA)ELISA检测试剂盒RabbitAi-SmoothMuscleAibody,ASMAELISAKit 96T/48T
RatGelsolinELISA试剂盒大鼠凝溶胶蛋白(Gelsolin)ELISA试剂盒规格:96T/48T 小构树醇A HPLC≥95% 20mg
Ratghcagons-likepepfide1,GLP-1大鼠胰高血糖素样肽1(Glp-1)ELISA试剂盒规格:96T/48T 疏展香茶菜宁B HPLC≥95% 20mg
Ratghcagons-likepepfide1,GLP-1ELISA试剂盒大鼠胰高血糖素样肽1(Glp-1)ELISA试剂盒规格:96T/48T 延命草素 HPLC≥95% 20mg
Ratglamicaciddecarboxylaseaoaibody,GAD-Ab大鼠谷氨酸脱羧酶自身抗体(GAD-Ab)ELISA试剂盒规格:96T/48T ,,三羟基',,三甲氧基黄酮 HPLC≥95% 20mg
Ratglamicaciddecarboxylaseaoaibody,GAD-AbELISA试剂盒大鼠谷氨酸脱羧酶自身抗体(GAD-Ab)ELISA试剂盒规格:96T/48T 竹红菌丙素 HPLC≥95% 20mg
Ratglialcellline-derivedneuroophicfactor,GDNF大鼠胶质细胞系来源的神经营养因子(GDNF)ELISA试剂盒规格:96T/48T 显轴买麻藤醇 HPLC≥95% 20mg
Ratglialcellline-derivedneuroophicfactor,GDNFELISA试剂盒大鼠胶质细胞系来源的神经营养因子(GDNF)ELISA试剂盒规格:96T/48T 甲基 O阿魏酰奎尼酸酯 HPLC≥95% 20mg
Ratglucocoicoid,GC大鼠内源性糖皮质激素(GC)ELISA试剂盒规格:96T/48T 甲基 O阿魏酰奎尼酸酯 HPLC≥95% 20mg
Ratglucocoicoid,GCELISA试剂盒大鼠内源性糖皮质激素(GC)ELISA试剂盒规格:96T/48T 槲皮素O芸香糖苷 HPLC≥95% 20mg
Ratglucocoicoidreceptor,GR大鼠糖皮质类受体(GR)ELISA试剂盒规格:96T/48T 异直立角茴香碱 HPLC≥95% 20mg
绒毛木霉图片英文名称Humanai-thrombieceptorELISAKit人抗凝血酶受体(A)规格:96T/48T 去甲汉黄芩素 HPLC≥95% 20mg
低分子蛋白标准样100 补骨脂色烯查耳酮 HPLC≥95% 20mg
RatOsteopoin,OPNELISA试剂盒大鼠骨桥素(OPN)ELISA试剂盒规格:96T/48T 异补骨脂色烯查耳酮 HPLC≥95% 20mg
小鼠细胞骨架活性调节蛋白(ARC)ELISA试剂盒 ,英文名: ARC ELISA Kit 异新补骨脂异黄酮 HPLC≥95% 20mg
兔抗内皮细胞抗体(AECA)ELISA检测试剂盒RabbitAi-endothelialcellaibodies,AECAELISAKit 96T/48T 羟基羽扇豆鹼 HPLC≥95% 20mg
牛雄(ASD)试剂盒 Bovine Androstenedione,ASD ELISA Kit 灵芝酸TR HPLC≥95% 20mg
英文名称HumanAT-IIIELISAKit人抗凝血酶(AT-III)ELISA试剂盒规格:96T/48T 灵芝烯酸A HPLC≥95% 20mg
低内小量质粒抽提试剂盒20/50 灵芝酸TQ HPLC≥95% 20mg
RatOsteoprotegerinLigand,OPGLELISA试剂盒大鼠骨保护素配体(OPGL)ELISA试剂盒规格:96T/48T 灵芝烯酸C HPLC≥95% 20mg
小鼠细胞分裂周期因子25(CDC25)ELISA试剂盒 ,英文名: CDC25 ELISA Kit Delta avenasterol HPLC≥95% 20mg
我公司专业代理ATCC菌种,价格优惠,绒毛木霉图片质量保证,为大中型科研提供严格质量体系控制的ATCC,CMCC,CICC,DSMZ标准菌株。
1.供货及时。我们订货周期短,运输时间短,在最短时间内为您提供所需产品。
2.价格优惠:我公司是ScienCell和美国ATCC的中国代理商,没有中间环节。在国内我们保证价格最低。
3.服务保障:我们拥有专用的技术指导团队,对每售出的一件产品,提供全面的售前、售中和售后服务。
4.产品种类齐全:25个系统共150多种细胞,满足不同客户的要求。细胞经过严格的质控,纯度可达98%。常用产品备有现货。其产品类型如下:消化系统细胞株,呼吸系统细胞株,泌尿系统细胞株生殖系统细胞株 血液循环系统 内皮细胞细胞株 神经系统及其他细胞株,动物细胞株和菌株。
中文名称 绒毛木霉图片
种属 Trichoderma│tomentosum
分离基物 生物样/无瓣海桑-泥
提供形式 斜面培养物
模式菌株 no
应用领域 近海丝状真菌
培养方法
培养基 14
生长条件 25℃
存储条件 液氮超低温冻结法;-80℃冰箱冻结法
菌种的传代:
将微生物接种至一新鲜培养基上/内,每萌发一次即为一代
菌种的传代次数(自原始的菌种冻干粉起)不得超过5代
菌种保藏方法一般分四个阶段
(1)挑选特征典型的纯菌菌落
(2)能产生孢子或芽孢的微生物应用孢子或芽孢进行保存
(3)选择最适宜的方法保藏
(4)定期对保藏菌种进行检查
低温保存法:
1.简单保存法,将琼脂斜面孢子培养物、菌丝悬浮液以及由麸皮、大米、小米等谷物原料制成的孢子培养物置于4℃冰箱保存,保存时间不超过1~2个月,若将谷物原料制备的孢子瓶抽真空并在棉塞上浸蜡,以隔绝外界空气和水汽,保持时间可达3~4个月。
2.液氮超低温保存法,将生长稳定期的细胞悬浮在10%甘油或其他低冰点液体中,密封于安瓿管内,然后控制冷却速度,使安瓿管温度逐步下降至-35℃时,即可置于-150~-196℃的液氮罐中保存。大多数微生物如病毒、噬菌体、多种细菌、放线菌、酵母和原虫、特别是一些用冷冻干燥法有困难的微生物,都可用此法长期保存。
使用范围:
(1)合成培养基。合成培养基的各种成分完全是已知的各种化学物质。这种培养基的化学成分清楚,酿酒酵母菌组成成分精确,重复性强,而且微生物在这类培养基中生长较慢。如高氏一号合成培养基、察氏(Czapek)培养基等。
(2)天然培养基。由天然物质制成,如蒸熟的马铃薯和普通牛肉汤,前者用于培养霉菌,后者用于培养细菌。这类培养基的化学成分很不恒定,也难以确定,但配制方便,营养丰富,培养效果好,所以常被采用。
(3)半合成培养基。在天然有机物的基础上适当加入已知成分的无机盐类,或在合成培养基的基础上添加某些天然成分,如培养霉菌用的马铃薯葡萄糖琼脂培养基。这类培养基能更有效地满足微生物对营养物质的需要。
疏展香茶菜宁B HPLC≥95% 20mg Ratghcagons-likepepfide1,GLP-1ELISAKit大鼠胰高血糖素样肽1(Glp-1)ELISA试剂盒规格:96T/48T
延命草素 HPLC≥95% 20mg Ratghcagons-likepepfide1,GLP-1ELISA试剂盒大鼠胰高血糖素样肽1(Glp-1)ELISA试剂盒规格:96T/48T
,,三羟基',,三甲氧基黄酮 HPLC≥95% 20mg Ratglamicaciddecarboxylaseaoaibody,GAD-AbELISAKit大鼠谷氨酸脱羧酶自身抗体(GAD-Ab)ELISA试剂盒规格:96T/48T
竹红菌丙素 HPLC≥95% 20mg Ratglamicaciddecarboxylaseaoaibody,GAD-AbELISA试剂盒大鼠谷氨酸脱羧酶自身抗体(GAD-Ab)ELISA试剂盒规格:96T/48T
显轴买麻藤醇 HPLC≥95% 20mg Ratglialcellline-derivedneuroophicfactor,GDNFELISAKit大鼠胶质细胞系来源的神经营养因子(GDNF)ELISA试剂盒规格:96T/48T
甲基 O阿魏酰奎尼酸酯 HPLC≥95% 20mg Ratglialcellline-derivedneuroophicfactor,GDNFELISA试剂盒大鼠胶质细胞系来源的神经营养因子(GDNF)ELISA试剂盒规格:96T/48T
甲基 O阿魏酰奎尼酸酯 HPLC≥95% 20mg Ratglucocoicoid,GCELISAKit大鼠内源性糖皮质激素(GC)ELISA试剂盒规格:96T/48T
槲皮素O芸香糖苷 HPLC≥95% 20mg Ratglucocoicoid,GCELISA试剂盒大鼠内源性糖皮质激素(GC)ELISA试剂盒规格:96T/48T
异直立角茴香碱 HPLC≥95% 20mg Ratglucocoicoidreceptor,GRELISAKit大鼠糖皮质类受体(GR)ELISA试剂盒规格:96T/48T
直立角茴香碱 HPLC≥95% 20mg Ratglucocoicoidreceptor,GRELISA试剂盒大鼠糖皮质类受体(GR)ELISA试剂盒规格:96T/48T
补骨脂色烯查耳酮 HPLC≥95% 20mg 低分子蛋白标准样100
异补骨脂色烯查耳酮 HPLC≥95% 20mg RatOsteopoin,OPNELISA试剂盒大鼠骨桥素(OPN)ELISA试剂盒规格:96T/48T
异新补骨脂异黄酮 HPLC≥95% 20mg 小鼠细胞骨架活性调节蛋白(ARC)ELISA试剂盒 ,英文名: ARC ELISA Kit
羟基羽扇豆鹼 HPLC≥95% 20mg 兔抗内皮细胞抗体(AECA)ELISA检测试剂盒RabbitAi-endothelialcellaibodies,AECAELISAKit 96T/48T
灵芝酸TR HPLC≥95% 20mg 牛雄(ASD)试剂盒 Bovine Androstenedione,ASD ELISA Kit
灵芝烯酸A HPLC≥95% 20mg 英文名称HumanAT-IIIELISAKit人抗凝血酶(AT-III)ELISA试剂盒规格:96T/48T
灵芝酸TQ HPLC≥95% 20mg 低内小量质粒抽提试剂盒20/50
灵芝烯酸C HPLC≥95% 20mg RatOsteoprotegerinLigand,OPGLELISA试剂盒大鼠骨保护素配体(OPGL)ELISA试剂盒规格:96T/48T
Delta avenasterol HPLC≥95% 20mg 小鼠细胞分裂周期因子25(CDC25)ELISA试剂盒 ,英文名: CDC25 ELISA Kit
Delta avenasterol HPLC≥95% 20mg 兔抗平滑肌抗体(ASMA)ELISA检测试剂盒RabbitAi-SmoothMuscleAibody,ASMAELISAKit 96T/48T
RatGelsolinELISA试剂盒大鼠凝溶胶蛋白(Gelsolin)ELISA试剂盒规格:96T/48T 小构树醇A HPLC≥95% 20mg
Ratghcagons-likepepfide1,GLP-1大鼠胰高血糖素样肽1(Glp-1)ELISA试剂盒规格:96T/48T 疏展香茶菜宁B HPLC≥95% 20mg
Ratghcagons-likepepfide1,GLP-1ELISA试剂盒大鼠胰高血糖素样肽1(Glp-1)ELISA试剂盒规格:96T/48T 延命草素 HPLC≥95% 20mg
Ratglamicaciddecarboxylaseaoaibody,GAD-Ab大鼠谷氨酸脱羧酶自身抗体(GAD-Ab)ELISA试剂盒规格:96T/48T ,,三羟基',,三甲氧基黄酮 HPLC≥95% 20mg
Ratglamicaciddecarboxylaseaoaibody,GAD-AbELISA试剂盒大鼠谷氨酸脱羧酶自身抗体(GAD-Ab)ELISA试剂盒规格:96T/48T 竹红菌丙素 HPLC≥95% 20mg
Ratglialcellline-derivedneuroophicfactor,GDNF大鼠胶质细胞系来源的神经营养因子(GDNF)ELISA试剂盒规格:96T/48T 显轴买麻藤醇 HPLC≥95% 20mg
Ratglialcellline-derivedneuroophicfactor,GDNFELISA试剂盒大鼠胶质细胞系来源的神经营养因子(GDNF)ELISA试剂盒规格:96T/48T 甲基 O阿魏酰奎尼酸酯 HPLC≥95% 20mg
Ratglucocoicoid,GC大鼠内源性糖皮质激素(GC)ELISA试剂盒规格:96T/48T 甲基 O阿魏酰奎尼酸酯 HPLC≥95% 20mg
Ratglucocoicoid,GCELISA试剂盒大鼠内源性糖皮质激素(GC)ELISA试剂盒规格:96T/48T 槲皮素O芸香糖苷 HPLC≥95% 20mg
Ratglucocoicoidreceptor,GR大鼠糖皮质类受体(GR)ELISA试剂盒规格:96T/48T 异直立角茴香碱 HPLC≥95% 20mg
绒毛木霉图片英文名称Humanai-thrombieceptorELISAKit人抗凝血酶受体(A)规格:96T/48T 去甲汉黄芩素 HPLC≥95% 20mg
低分子蛋白标准样100 补骨脂色烯查耳酮 HPLC≥95% 20mg
RatOsteopoin,OPNELISA试剂盒大鼠骨桥素(OPN)ELISA试剂盒规格:96T/48T 异补骨脂色烯查耳酮 HPLC≥95% 20mg
小鼠细胞骨架活性调节蛋白(ARC)ELISA试剂盒 ,英文名: ARC ELISA Kit 异新补骨脂异黄酮 HPLC≥95% 20mg
兔抗内皮细胞抗体(AECA)ELISA检测试剂盒RabbitAi-endothelialcellaibodies,AECAELISAKit 96T/48T 羟基羽扇豆鹼 HPLC≥95% 20mg
牛雄(ASD)试剂盒 Bovine Androstenedione,ASD ELISA Kit 灵芝酸TR HPLC≥95% 20mg
英文名称HumanAT-IIIELISAKit人抗凝血酶(AT-III)ELISA试剂盒规格:96T/48T 灵芝烯酸A HPLC≥95% 20mg
低内小量质粒抽提试剂盒20/50 灵芝酸TQ HPLC≥95% 20mg
RatOsteoprotegerinLigand,OPGLELISA试剂盒大鼠骨保护素配体(OPGL)ELISA试剂盒规格:96T/48T 灵芝烯酸C HPLC≥95% 20mg
小鼠细胞分裂周期因子25(CDC25)ELISA试剂盒 ,英文名: CDC25 ELISA Kit Delta avenasterol HPLC≥95% 20mg
我公司专业代理ATCC菌种,价格优惠,绒毛木霉图片质量保证,为大中型科研提供严格质量体系控制的ATCC,CMCC,CICC,DSMZ标准菌株。
风险提示:丁香通仅作为第三方平台,为商家信息发布提供平台空间。用户咨询产品时请注意保护个人信息及财产安全,合理判断,谨慎选购商品,商家和用户对交易行为负责。对于医疗器械类产品,请先查证核实企业经营资质和医疗器械产品注册证情况。
技术资料暂无技术资料 索取技术资料
绒毛木霉图片
询价